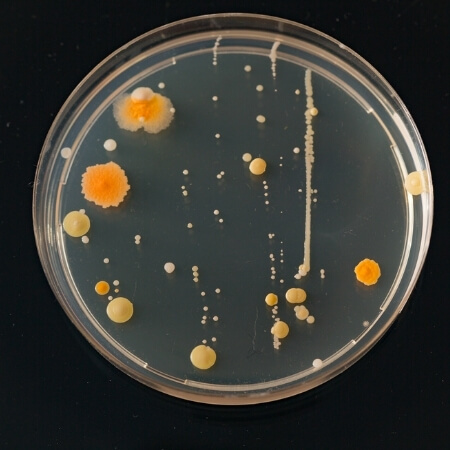

Certificados
Concepto favorable de la Secretaría de Salud de Bogotá y Cundinamarca
Concepto favorable de la Secretaría de Salud de Bogotá y Cundinamarca
Somos especialistas
en control de plagas
VISITA DE COTIZACIÓN SIN COSTO EN BOGOTÁ
📞 Llámanos Ahora
Nuestros servicios

La lucha contra los rodeores es un problema en salud pública
que ha tenido un nuevo enfoque, pues se trata de disminuir el factor de riesgo de transmisión de enfermedades a través de estos y no de eliminar a toda la población, ya que cumplen un papel importante dentro de la cadena biológica.
Su control se realiza por medio de cebos preparados con diferentes atrayentes para garantizar que el roedor coma el producto y muera.

Según el decreto 1575 del 9 de mayo de 2007 los tanques para almacenamiento de agua potable aéreos y subterráneos deben lavarse y desinfectarse mínimo cada seis meses, con control especializado.
¡Te ayudamos!

Un control integrado de plagas de vectores específico de insectos voladores y rastreros se realizará mediante sistemas de combate utilizando todas las técnicas, métodos y prácticas de saneamiento ambiental adecuados para eliminar o mantener los niveles de infestación bajos que no causen perjuicios al ser humano.

Es indispensable su utilización para el saneamiento básico que tiene como finalidad la destrucción de los microorganismos patógenos (bacterias, virus y hongos) en todos los ambientes que puedan resultar nocivos mediante la utilización de agentes fundamentalmente químicos, tanto en el área total de la empresa como de áreas críticas.
Se realiza un control por medio de aspersión o nebulización.

Si ha identificado un panal de abejas tenga en cuenta las siguientes recomedaciones:
– Apague todas las luces a su alrededor.
– Acordone el área.
– NO utilice linternas por tiempos prolongados.
Contáctanos, te ayudaremos a retirar el enjambre y realizar un control efectivo.
La húmedad o calor favorecen la formación de hongos y bacterias que acidifican los pápeles. Hay más de 200 especies de hongos que pueden dañar tus documentos.
Para controlar archivos sin dañar los documentos usamos técnicas por medio de vapor, limpieza y desinfección de superficies liberando cargas de polvo o contaminantes biológicos.
También por medio de humo para mayor penetración del producto controlamos insectos como termitas o gorgojos.

Contamos con los elementos fundamentales para el cumplimiento de las normas HACCP, BMP y AIB.
Tenemos a tu disposición: Lámparas atrapa insectos, caja cebadera para roedores, láminas de pegamento, eliminador de olores, cebos y jeringa para el control de cucarachas y hormigas.

Clase A: Para tipos de fuegos con combustibles sólidos como madera, cartón, plástico, etc.
Clase B: Para tipo de fuego donde el combustible es líquido por ejemplo aceite, gasolina o pintura.
Clase C: Para tipo de fuego donde el combustible son gases como butano, propano o gas ciudad.
Clase F: Para tipo de fuego derivado de aceites y grasas (vegetales o animales) en cocinas y almacenamiento de aceites.
Clase D: Son los más raros, el combustible es un metal como magnesio, sodio o aluminio e polvo.

Los gatos callejeros que han vivido cerca de los humanos se consideran salvajes, estos se pueden volver a domesticar, por ello se realiza la captura del gato sin causarle ningún daño para luego entregarlo a una entidad protectora de animales que se encarga de la socialización del animal hasta su adopción.

Usamos productos especializados para el control de palomas OVOCONTROL, traído especialmente de E.U, considerado como un anticonceptivo para palomas que NO mata a las existentes, sino que controla la puesta de huevos y el crecimiento de la especie.
Se garantiza una reducción de la población del 50% al cabo de 1 año y de un 90% al cabo de 2 años.

Se realiza el control de insectos en transporte de pasajeros y desinfección en transporte de alimentos.
Se emite certificado para la empresa afiliada y para el dueño del vehículo.
Usamos método por aspersión.
Nuestros Clientes
1991
AÑO DE FUNDADA
30 Años
DE EXPERIENCIA
100%
CLIENTES SATISFECHOS